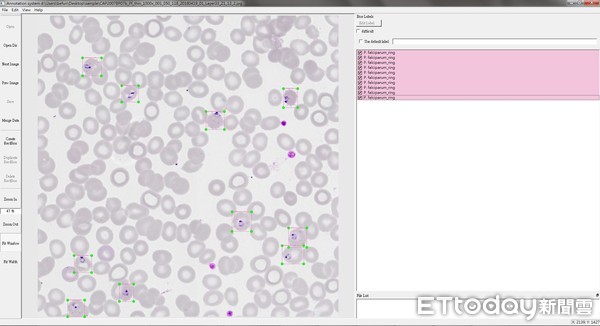
▲瘧原蟲標記畫面。(圖/疾管署提供)

▲ AI人工智慧揪出瘧疾,疾管署「鷹眼專家」終能退休了。(攝影/劉亮亨、莊喬迪、張凱喨;製作/張舒芸;資料提供/疾管署)
記者嚴云岑/專題報導
瘧疾為台灣法定傳染病,雖在1965年根除,每年仍有10至30例境外移入病例。一旦醫院收到疑似病例,需將影像檔送至疾管署,以人眼判讀是否感染,但隨著署內唯一的「鷹眼專家」郭明珠即將退休,疾管署尋求外援,改用人工智慧輔助,經過半年多的訓練,電腦判讀惡性瘧原蟲準確度超過9成,未來有望領先全球建立瘧疾血片資料庫,展現台灣軟實力。
瘧疾感染為遭帶有瘧原蟲的蚊子叮咬後,紅血球被指環體佔領,進而出現一系列發燒、冒冷汗、肌肉痠痛、噁心嘔吐症狀。若無適當治療,嚴重者可能導致黃疸、休克、肝腎衰竭、肺水腫、急性腦病變,並可能造成死亡,但只要及時投藥,基本上一天內就能緩解。
台灣近年來揪出的瘧疾案例,多是以高燒作為表徵,其中又以惡性瘧、間日瘧為大宗。醫院鏡檢患者血液發現疑似案例,除需依《傳染病防治法》將檢體送疾管署,還須在第一時間拍下顯微鏡影像由專家進行判讀,確認感染期別及型別,好對患者進行投藥,若檢體在深夜送到,專家也需趕回疾管署進行研判。

▲疾管署副署長莊人祥。(圖/記者季相儒攝)
計畫發起人、疾管署副署長莊人祥表示,AI人工智慧的著力點在於最後一階段的輔助判讀,未來模型建置完成,不排除開放給醫院直接套用,讓醫事人員一驗就知中標與否,縮短投藥時間。
人工智慧判讀瘧疾,需由大數據做為輔助,而這些數據全仰賴疾管署提供。疾管署與人工智慧實驗室去年7月申請科技部計畫通過,今年1月正式投入影像掃描,但光是前置作業,就遇到不少難關。
計畫負責人、防疫醫師劉宇倫表示,瘧疾血片鏡檢需使用100倍物鏡,清晰觀察寄生於紅血球的瘧原蟲,但一般組織病理切片掃描物鏡多為40倍,一開始找不到適合的電動顯微鏡,只能靠廠商提供的舊機器,以4平方毫米網格慢慢掃描,加上高倍率掃描容易因環境震動,影響玻片對焦品質,每次掃片會以Z-stack模式儲存3個焦層,增加準確率,光掃一片血液抹片,就需耗上4至6小時。

▲疾管署瘧疾血片資料庫建置步驟。(圖/疾管署劉宇倫醫師提供)
除了掃描花時間,影像庫建立作業也是一大問題。劉宇倫提到,掃描後的影像將依每個網格分層,切割為2048X2048單位的jpg檔,再對瘧原蟲位置進行標記,由於影像檔案極大,轉檔上傳過程讓電腦數度當機,後來改採隨身硬碟儲存,才成功將影像提供給人工智慧實驗室進行分析。
疾管署1月至今已掃描50片血片,共計570萬張影像檔,成功標記出3000多片惡性瘧原蟲。劉宇倫笑稱,為了方便電腦學習,掃描的都是「教科書」等級,指環體在紅血球清晰可見。不過,瘧原蟲在血液中除了第一階段指環體外,尚有活動體、分裂體、配子體、生殖母細胞等階段,有些保存過久或染色不佳的抹片,都需專家指點,才能將血片中的瘧原蟲一網打盡。
劉宇倫提到,瘧原蟲找到宿主後,多以指環體存在於血球中,蟲體逐漸長大為成熟活動體,其核染質與細胞質開始分裂為分裂體,分裂體破裂後分裂小體被釋出於血液中,如此在紅血球內的分裂繁殖稱紅血球內分裂繁殖,然後分裂小體又進入新紅血球內發育,反覆其分裂繁殖至人體產生的免疫或被抗瘧藥物抑制為止。
▲疾管署在掃描血片時,需手動一張張標記出瘧原蟲。(圖/疾管署提供)
疾管署瘧疾唯一判讀專家、檢驗及疫苗研製中心寄生蟲實驗室辦事員郭明珠謙稱,通常醫院送來的瘧疾血片都在指環體階段,能夠一眼就揪出,也是靠46年的經驗,加上顯微鏡近年來已有大幅進展,「我從不好的看到好的,辨識上當然更容易。」
不過,郭明珠也分享辨識撇步,像是台灣常見的間日瘧,因為原蟲喜歡寄生在年輕、幼小的紅血球上,顯微鏡下的血球會成不規則狀,而血性斑點也是判斷關鍵。至於惡性瘧則容易遭到血小板、染色雜質相互干擾,此時就要從核、細胞質、色素等三要件辨識。

▲疾管署防疫醫師劉宇倫指出電腦標記出的瘧原蟲。(圖/記者季相儒攝)
疾管署將掃描血片歸檔後,便送往人工智慧實驗室進行後續模組建置,若通過圖靈測試,電腦判讀準確率高過人類,就代表模組成功。人工智慧實驗室董事長杜奕瑾表示,1月至今已利用10多片血片、20多萬張圖檔幫模型建檔,目前已拿資料庫血片隨機測試,準確率已接近專業醫師水準。
人工智慧實驗室研究員郭柏辰表示,系統是利用已標記的瘧原蟲血片建置初步物件物件偵測模型,電腦接收血片後,會快速掃每一處影像,挑出可疑點做分類,最終再從中判定是否有血球遭感染。實驗室將判讀成果提供給郭明珠做最終確認,有9成5以上的瘧原蟲都能成功挑出 ,由於判讀不需要挑出全部瘧原蟲 ,就確診要求而言,已接近專業醫師判讀。

▲人工智慧實驗室董事長杜奕瑾。(圖/記者黃克翔攝)
杜奕瑾舉例,教電腦分辨瘧原蟲就像教小孩,拿著兩張不同的圖檔,告訴他「這個是,這個不是。」由於指環體辨識不易,過去的確發生將雜質誤判成瘧原蟲案例,但此時就要更有耐心,讓誤判圖檔混搭正確圖檔反覆出現,直到電腦完全學會為止。
疾管署現存瘧疾血片共有4000多片,預計掃描200片作為瘧疾AI辨識資料庫,但杜奕瑾坦言,「不需要這麼多」,因為大數據首重多樣性,「有些血片長很像,對資料其實沒什麼幫助 ,需收集不同種類來源的血片。」
瘧疾AI系統在7月16日在疾管署展開首次測試,利用未判讀過的血片展開人機對決,除了比快還要比準。杜奕瑾表示,人工智慧實驗室預計在10月發表完整成果,屆時一定能達到圖靈測試標準。

▲疾管署電子顯微鏡掃描瘧疾血片,一張就要花4至6小時。(圖/疾管署提供)
對於AI在醫療發展願景,杜奕瑾說,台灣除了瘧疾外,還有許多已根除的法定傳染病,隨著專家人數逐日凋零,人工智慧實驗室想做的,就是「把逐漸失傳的醫師智慧學習起來」,至於下一步要做什麼?還有待與疾管署討論。而瘧疾資料庫建置完成後,將免費開放給全台甚至全球醫療院所使用,讓智慧醫材創造更高的附加價值。
至於人工智慧判讀結果是否仍人類做最後把關?杜奕瑾笑答,「不一定」,依照過去經驗,只要機器準確度達到一定水準,就不需人類判讀,像機場自動通關就是如此。不過,瘧疾判讀因牽涉到醫材,是否能完全將「人」抽離,還需通過食藥署審查才能放行。

▲疾管署與人工智慧實驗室合作,讓電腦學習揪出血液中的瘧原蟲,服務46年的專家終於能安心退休了。(圖/記者黃克翔攝)









讀者迴響